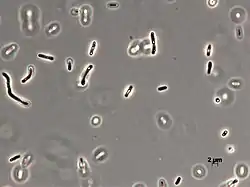

| Aquabacterium | ||
|---|---|---|
| ||
| Taxonomía | ||
| Dominio: | Bacteria | |
| Filo: | Pseudomonadota | |
| Clase: | Betaproteobacteria | |
| Orden: | Burkholderiales | |
| Familia: | Comamonadaceae | |
| Género: | Aquabacterium | |
| Especies | ||
A. citratiphilum | ||
Aquabacterium es un género de bacterias gramnegativas de la familia Comamonadaceae. Fue descrito en el año 1999. Su etimología hace referencia a agua.[1] Son bacterias aerobias, y en general móviles por flagelo polar. Son mesófilas, aunque la especie Aquabacterium tepidiphilum es ligeramente termófila. Originalmente se aisló de biofilms en instalaciones de agua potable doméstica en Berlín. También se pueden encontrar en fuentes de agua dulce y suelos.
Taxonomía
Actualmente hay 11 especies descritas en este género:
- Aquabacterium citratiphilum
- Aquabacterium commune
- Aquabacterium fontiphilum
- Aquabacterium lacunae
- Aquabacterium limnoticum
- Aquabacterium olei
- Aquabacterium parvum
- Aquabacterium pictum
- Aquabacterium soli
- Aquabacterium tepidiphilum
- Aquabacterium terrae
Referencias
- ↑ Kalmbach, S.; Manz, W.; Wecke, J.; Szewzyk, U. (1999-04). «Aquabacterium gen. nov., with description of Aquabacterium citratiphilum sp. nov., Aquabacterium parvum sp. nov. and Aquabacterium commune sp. nov., three in situ dominant bacterial species from the Berlin drinking water system». International Journal of Systematic Bacteriology. 49 Pt 2: 769-777. ISSN 0020-7713. PMID 10319501. doi:10.1099/00207713-49-2-769. Consultado el 11 de diciembre de 2022.
Este artículo ha sido escrito por Wikipedia. El texto está disponible bajo la licencia Creative Commons - Atribución - CompartirIgual. Pueden aplicarse cláusulas adicionales a los archivos multimedia.